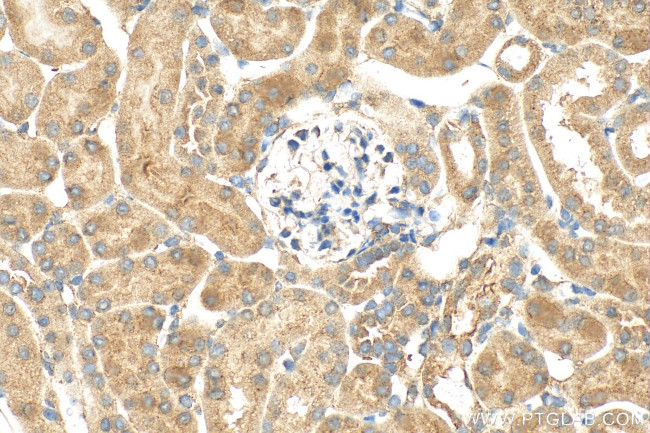
FNIP2 Antibody in Immunohistochemistry (Paraffin) (IHC (P))

Search
Proteintech
FNIP2 Polyclonal Antibody
{{$productOrderCtrl.translations['antibody.pdp.commerceCard.promotion.promotions']}}
{{$productOrderCtrl.translations['antibody.pdp.commerceCard.promotion.viewpromo']}}
{{$productOrderCtrl.translations['antibody.pdp.commerceCard.promotion.promocode']}}: {{promo.promoCode}} {{promo.promoTitle}} {{promo.promoDescription}}. {{$productOrderCtrl.translations['antibody.pdp.commerceCard.promotion.learnmore']}}
产品信息
31283-1-AP
种属反应
宿主/亚型
分类
类型
抗原
偶联物
形式
浓度
纯化类型
保存液
内含物
保存条件
运输条件
产品详细信息
Immunogen sequence: ERVKACGPSL EASEAADVAQ DPQVSRSPFK PGFQENVCCP QNRLSEGDEG ESDKGFAEDR GSRNDMAADI AGQLSHAADL GTASHGAGGT GGRRLEATRG LYVKAAEGPV LEPVAPRCVQ RGPGLVAGAN IPCGDDNKKA NFRTEG
靶标信息
FNIP2 is the second protein found to interact with folliculin, the product of the Birt-Hogg-Dube (BHD) gene. Folliculin is thought to act as a tumor suppressor as mutations or loss of heterozygosity in this gene are associated with BHD syndrome-related renal tumors. Folliculin and FNIP1, a protein that shares 49% identity to FNIP2, bind to AMPK, an important energy sensor in cells that negatively regulates the mammalian target of rapamycin (mTOR), a protein that is thought to be the master switch for cell growth and proliferation. FNIP1 and FNIP2 are able to form homo- and heteromeric multimers, suggesting these proteins may have a functional relationship.
仅用于科研。不用于诊断过程。未经明确授权不得转售。
篇参考文献 (0)
生物信息学
蛋白别名: FNIP1-like protein; Folliculin-interacting protein 2; O6-methylguanine-induced apoptosis 1 protein
基因别名: D630023B12Rik; FNIP2; FNIPL; KIAA1450; MAPO1; mKIAA1450
UniProt ID: (Human) Q9P278, (Mouse) Q80TD3
Entrez Gene ID: (Human) 57600, (Mouse) 329679